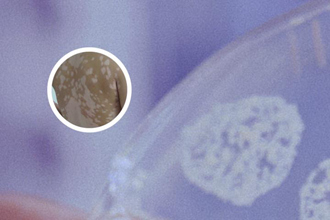

308光療是激光嗎

白癜風,給患者造成了很大的困擾和痛苦。近年來,一種叫做308光療的治療方法越來越受到關注。然而,很多患者對于308光療到底是不是激光治療還存在疑慮。本文將從多個維度探討這個問題,幫助患者了解308光療的原理和效果。
1. 什么是308光療?
308光療是一種利用eCl準分子激光器產(chǎn)生的308nm波長的紫外線療法。相比于傳統(tǒng)的UVB療法,308光療波長更短,能更好地被皮膚吸收,針對性更強,因此具有更高的治療結果。
2. 308光療與激光有何不同?
盡管308光療使用的是激光器產(chǎn)生的紫外線波長,但是它并不屬于激光治療。激光治療是利用激光器產(chǎn)生的單一波長光線,經(jīng)過特定調整后,針對性地治療疾病。而308光療是利用準分子激光器產(chǎn)生的特定波長紫外線,通過作用于皮膚細胞恢復免疫反應,治療白癜風。
3. 308光療的治療結果如何?
調查表明,308光療在治療白癜風方面有顯然的治療結果。它可以促進黑色素細胞的新發(fā),增加色素沉積,從而改善患者的皮膚色素失調癥狀。同時,308光療還具有抗炎作用,可以減緩炎癥反應,促進皮膚的恢復和新發(fā)。
4. 誰適合選擇308光療?
308光療對于白癜風患者來說是一種有效的治療方法。然而,并不是所有患者都適合選擇308光療。具體是否適宜使用308光療,應該在醫(yī)生的指導下進行判斷和決定,包括患者的病情、身體狀況和個人需求等因素。
308光療是一種非激光治療的方法,具有針對性強,治療結果顯然的特點。它可以幫助白癜風患者改善皮膚色素失調的問題,并促進炎癥的消退和皮膚的恢復。然而,選擇308光療治療白癜風應該在醫(yī)生的指導下進行,并根據(jù)個人情況進行決策。
對于白癜風患者來說,除了選擇適合的治療方法外,還應關注自身的生活等方面。建議患者要保持積極的心態(tài),尋求心理支持;加強學習了解關于白癜風的知識,提高對疾病的認識;在工作和學習上保持適度的壓力,避免過度勞累;家庭和生活方面要注重平衡和健康的生活方式。通過綜合的治療措施和積極的生活態(tài)度,患者可以更好地面對白癜風帶來的困擾,提高生活質量。
更多相關的信息和詳細解答,建議患者咨詢專業(yè)醫(yī)生或在專業(yè)的醫(yī)學網(wǎng)站、期刊上尋找可信的資料進行參考。記住,健康才是較重要的,不要輕可靠何未經(jīng)專業(yè)醫(yī)生認同的治療方法。
308光療是激光嗎
在治療白癜風的過程中,患者常常會遇到各種各樣的治療方法和技術,其中308光療是一種常見的治療方式。許多患者疑惑,308光療到底是激光嗎?為了解答這個問題,我們將從多個角度進行詳細分析。
1. 308光療與激光的原理
激光與308光療雖然在治療白癜風這一點上有一定的共性,但它們的原理確實不同的。激光是指通過產(chǎn)生強激光束,對人體皮膚進行選擇性吸收和破壞色素細胞或其他目標物,以達到治療目的的一種技術。而308光療則是指利用特定波長的eCl準分子激光,以聚焦的形式直接照射患者的皮膚表面,通過恢復和恢復受損的黑色素細胞,從而改善和恢復色素的生成功能。
2. 308光療與激光的效果比較
雖然激光和308光療都能有效治療白癜風,但它們的治療結果有所不同。激光治療通常會對皮膚進行創(chuàng)傷性損傷,并需要較長的恢復期。而308光療不會對皮膚造成創(chuàng)傷,治療過程中患者只會感受到輕微的溫熱感,且恢復期較短。308光療對于顯性白癜及面部白斑的治療結果也相對較好。
3. 308光療的治療機制與優(yōu)點
308光療作為一種較新的治療方法,在治療白癜風方面具有獨特的機制和優(yōu)點。該技術直接作用于患者的皮膚表面,通過恢復黑色素細胞,促進色素生成。相比其他治療方式,其治療結果可持續(xù),不易反復,并且沒有不錯的不良反應。308光療還具有操作簡單、治療時間短和高度可控的特點。
308光療與激光在治療白癜風方面存在一定的差異。雖然308光療并非激光技術,但它在治療結果、機制和優(yōu)點等方面都具備獨特的特點。因此,對于白癜風患者而言,選擇合適的治療方法是非常重要的。
在面對白癜風的治療過程中,患者除了選擇合適的治療方式外,還需要注意生活等維度。要保持積極的心態(tài),與醫(yī)生進行充分溝通,了解治療的過程和效果。要堅持規(guī)律的學習和工作,保持心情愉快,減少壓力的產(chǎn)生。同時,家人的關心和支持也是非常重要的,建議患者與家人一起參與治療過程,共同應對白癜風帶來的困擾。
雖然308光療并非激光技術,但在治療白癜風方面具備獨特的優(yōu)點和機制。對于白癜風患者而言,選擇適合自己的治療方法是關鍵,同時要在治療過程中注意生活等多個方面的平衡,以獲得更好的治療結果和生活質量。







